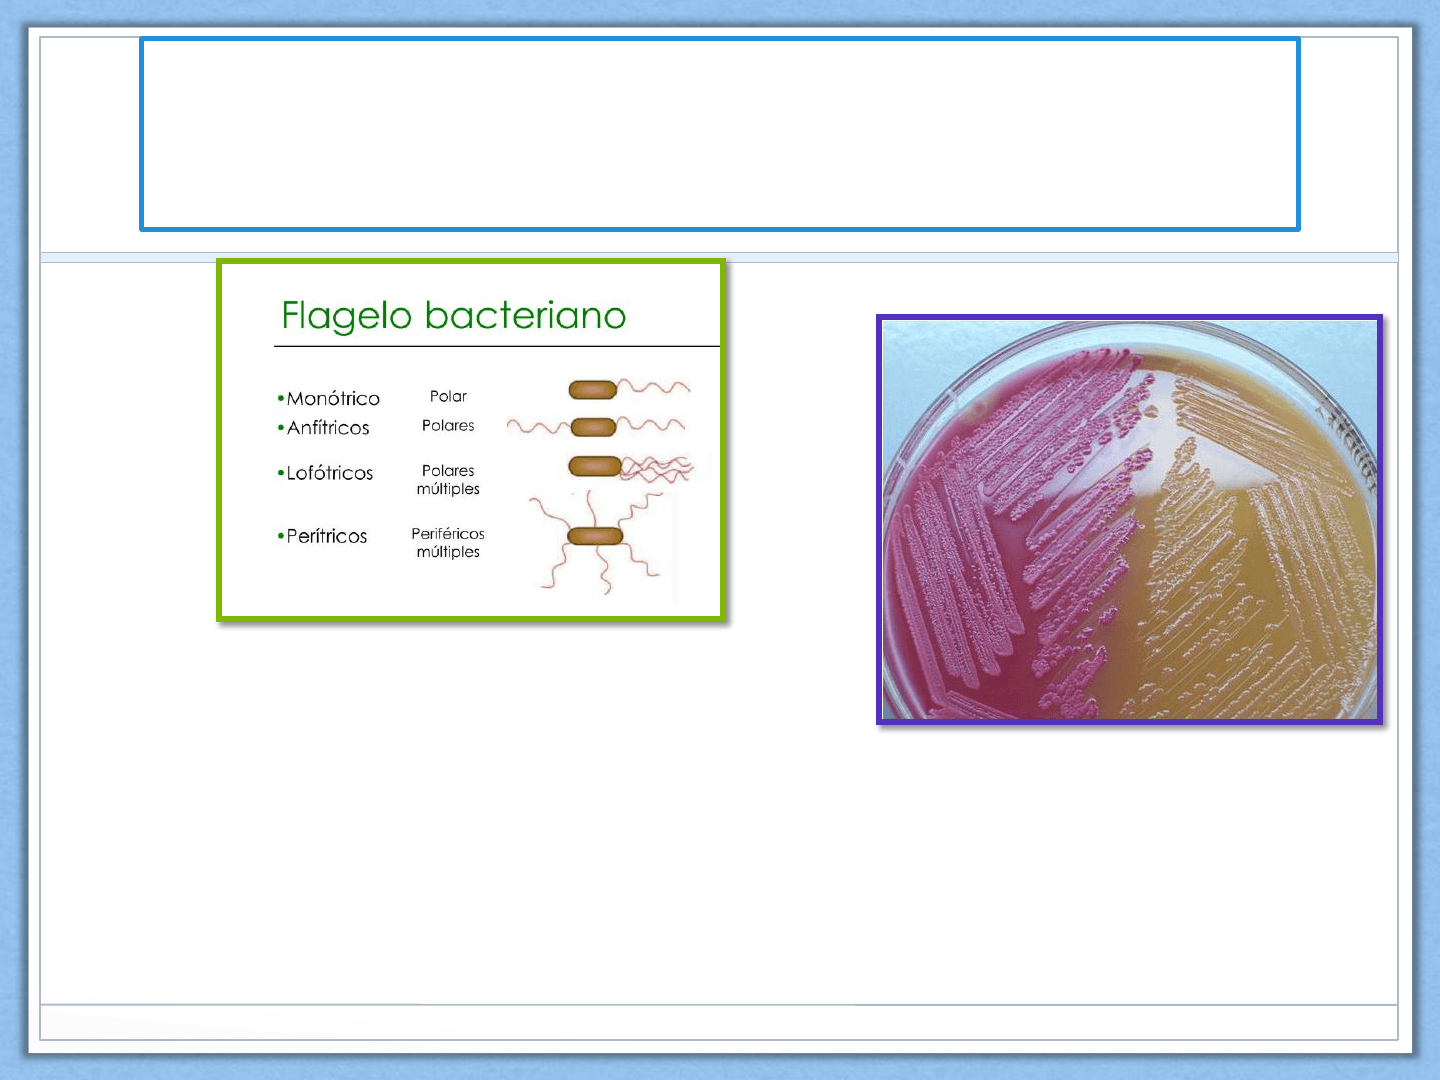

SEMINARIO Nº3
ENTEROBACTERIAS
Universidad Nacional de la Patagonia San Juan Bosco
Facultad de Ciencias Naturales y Ciencias de la Salud
Cátedra de Microbiología 2020

Contenidos
• Generalidades de
Enterobacterias
• Escherichia coli
• Shigella spp
• Salmonella spp
• Yersinia spp
• Klebsiella spp
• Reservorio
• Infecciones
• Factores de virulencia
• Patogenia

Generalidades de
Enterobacterias
• La familia Enterobacteriaceae esta constituída por 50 géneros y
cientos de especies.
• Son parte de la flora habitual intestinal de humanos y animales,
y también se encuentran en suelo, agua y vegetación.
• Son bacilos Gram negativos , anaerobios facultativos y no
esporulados.
• Desarrollan en medios de cultivo comunes (baja exigencia
nutricional).
• Se las clasifica en base a propiedades bioquímicas, estructura
antigénica, hibridación de DNA y secuenciación de ARNr 16s.
Generalidades de Enterobacterias
Características bioquímicas
• Capacidad de fermentar glucosa.
• Móviles por flagelos perítricos o inmóviles.
• Son oxidasa negativos y reducen nitratos (hay
excepciones).

Generalidades de Enterobacterias
• La mayoría de las enterobacterias se comportan como patógenos oportunistas ,
produciendo enfermedad frente a factores predisponentes del huésped (neutropenia,
cirrosis, etc) o factores de riesgo (catéter, sonda, cirugía, prótesis, heridas, etc).
• Otros miembros de la familia son patógenos primarios u obligados (Y. pestis,
S.Typhi, Shigella) no forman parte de la flora normal y su presencia indica infección.
• Otro grupo incluye a microorganismos comens ales que pueden pasar a ser
virulentos si adquieren ciertos mecanismos de patogenicidad a través de plásmidos,
transposones o fagos.
• Las infecciones en el ser humano se originan a partir de:
- Contacto animal
- Diseminación endógena a partir de intestino (ej infecciones urinarias y
bacteriemia por E.coli)
- A partir de portadores humanos que manejen alimentos (S.Typhi)
- Diseminación nosocomial.

Géneros y especies que con mayor frecuencia
se aíslan a partir de muestras clínicas humanas
Géneros
• Escherichia
• Shigella
• Salmonella
• Klebsiella
• Enterobacter
• Serratia
• Citrobacter
• Proteus
• Morganella
• Yersinia
Especies
• E. coli
• S. sonnei, S. dysenteriae
• S. enterica, S. bongori
• K. pneumoniae, K. oxytoca
• E. cloacae, E. aerogenes
• S. marcescens, S. odorifera
• C. freundii, C. kooseri
• P. vulgaris, P. mirabilis
• M. morganii
• Y. enterocolitica, Y. pestis

Enterobacterias
Estructura antigénica general
• Gram negativas

Enterobacterias
Estructura antigénica general
• El lipopolisacárido (LPS ) termoestable es el principal
antígeno de la pared celular y está formado por: el polisacárido
O somático más externo, un polisacárido central compartido
por todas las enterobacterias (antígeno común
enterobacteriano) y el lípido A.
• Antígeno K de la cápsula: polisacáridos
• Proteína H de los flagelos bacterianos: la movilidad es debida
a estos pero hay géneros que carecen de los mismos (Klebsiella,
Shigella).
• Los antígenos O y H permiten la identificación de serotipos
(serotipificación).
• También pueden presentar fimbrias (adherencia) y pili.

Enterobacterias
Factores determinantes de patogenicidad
• La cáps ula tiene propiedades de adhesina y es antifagocítica.
• Las fimbrias permiten la adherencia a la célula huésped.
• Algunas especies producen exoenzimas (ureasa, lipasa) permitiendo la
sobrevida de la bacteria.
• Producen aerobactinas que permiten captación de Hierro (Fe) desde el
medio.
• Sistema de secreción tipo III (Yersinia, Salmonella, Shigella, EPEC) poseen
un sistema efector común para trapasar o inyectar sus factores de
virulencia a la célula blanco o diana.
• Todas las enterobacterias poseen el LPS de pared, que posee acción de
endotoxina, se libera al destruirse la bacteria.
• No todas las especies producen exotoxinas , sólo son producidas por las
patógenas primarias.

Enterobacterias
Aislamiento e Identificación
• Gram
• Agar McConkey (medio de
cultivo selectivo y diferencial)
• Pruebas bioquímicas
- API

Escherichia coli
Escherichia coli

E.coli
• E.coli es uno de los
microorganismos más
frecuentemente aislados de
infecciones en el ser
humano.
• Existen otras especies del
género Escherichia
(E.hermanii, E.vulneris,
E.fergusonii, E.blattae,
E.albertii) pero son muy
raras.
• E.coli comensal forma parte
de la microbiota normal del
intestino.

E.coli

Escherichia coli
PATOGENIA
Infecciones intes tinales
• E.coli enteropatógena (ECEP)
• E.coli enterotoxigénica (ECET)
• E.coli enterohemorrágica
(ECEH)
• E.coli enteroinvasiva (ECEI)
• E.coli enteroagregativa (ECEA)
• E.coli adherencia difusa
(ECAD)
Infecciones urinarias
• E.coli uropatógena (ECUP)
Infecciones del SNC
• E.coli K1
Virotipos de E.coli
La evolución desde comensal a
patógena se relaciona a la
adquisición de factores de virulencia
por transferencia horizontal de genes
(plásmidos, bacteriófagos)

ECEP
• Vía de infección agua o
alimentos contaminados.
• Produce lesiones en el
intestino delgado por el
mecanismo de adherencia
(fimbrias) y borrado de
microvellosidades.
• Alteración de bomba de
iones y disminución de
absorción de agua.
• Diarrea acuosa frecuente en
niños.
Este documento contiene más páginas...
Descargar Completo
Seminario Enterobacterias.pdf
 Estamos procesando este archivo...
Estamos procesando este archivo...
 Lamentablemente la previsualización de este archivo no está disponible. De todas maneras puedes descargarlo y ver si te es útil.
Lamentablemente la previsualización de este archivo no está disponible. De todas maneras puedes descargarlo y ver si te es útil.
Descargar
 Estamos procesando este archivo...
Estamos procesando este archivo...
 Lamentablemente la previsualización de este archivo no está disponible. De todas maneras puedes descargarlo y ver si te es útil.
Lamentablemente la previsualización de este archivo no está disponible. De todas maneras puedes descargarlo y ver si te es útil.